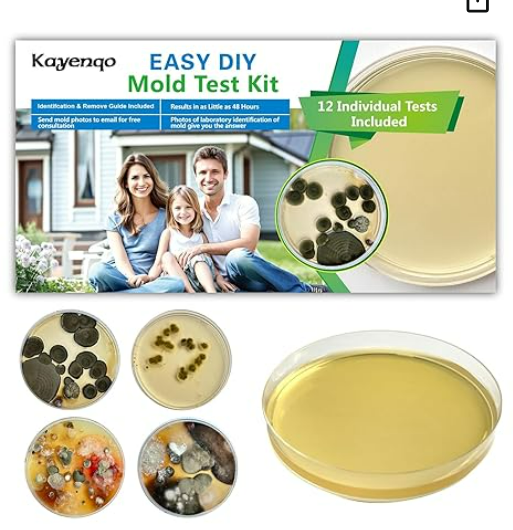

Mold, Mycotoxins, Liver Damage and Cancer Risk

Researched and written by Keith Bishop, Clinical Nutritionist, Cancer Coach, Retired Pharmacist, and Founder of Prevail Over Cancer.
Mold and fungus are more than just household nuisances — they may pose serious health risks, including contributing to cancer development. While not all mold exposure leads to disease, particular species produce mycotoxins, toxic compounds that have been linked to liver, kidney, and esophageal cancers. This Prevail Over Cancer blog post examines the science behind mold-related health risks, provides guidance on testing your environment and body, and offers actionable strategies to minimize exposure.
⚠️ Health Concerns Linked to Mold and Mycotoxins
Mold exposure can trigger:
- Respiratory issues: Asthma, sinusitis, chronic cough
- Neurological symptoms: Brain fog, memory loss, dizziness
- Immune dysfunction: Autoimmunity, frequent infections
- Hormonal imbalances: Fatigue, irregular cycles, blood sugar swings
- Skin issues: Rashes, itching, hives
- Cancer risks
- Mold exposure and mycotoxins can cause chronic inflammation, immune suppression, and toxin accumulation, which can contribute to cancer development.
- Breast cancer[i]
- Cervical cancer[ii]
- Kidney cancer and Renal cancer[iii]
- Liver cancer[iv] [v]
- Esophageal cancer[vi]
- Lung cancer[vii]
- Leukemia[viii]
- Lymphoma[ix]
Mycotoxins, Cancer and Virus Infections
Emerging research suggests that mycotoxin exposure may amplify the risk of virus-induced cancers by weakening immune defenses and promoting DNA damage that facilitates viral oncogenesis. Aflatoxin B1, for example, has been shown to synergize with hepatitis B virus (HBV), significantly increasing the risk of hepatocellular carcinoma (HCC) through enhanced p53 mutations and DNA adduct formation.[x] Similarly, immunosuppressive mycotoxins like ochratoxin A and aflatoxin may impair immune surveillance, potentially exacerbating the oncogenic effects of human papillomavirus (HPV) in cervical cancer and esophageal cancer.[xi]
Although direct links to Epstein–Barr virus (EBV)[xii] in esophageal cancer and nasopharyngeal carcinoma are still under investigation, the genotoxic and immunomodulatory properties of mycotoxins suggest a plausible role in viral cancer progression. These findings underscore the importance of assessing mold exposure in people with chronic viral infections, as co-exposure may compound cancer risk through overlapping molecular pathways.
Fenbendazole, Mycotoxins, and Liver Damage
Mounting evidence suggests that mycotoxin exposure may intensify the risk of liver damage in individuals using fenbendazole as part of integrative cancer care, especially those with preexisting hepatic vulnerabilities. Mycotoxins like gliotoxins and aflatoxins have been shown to impair liver detoxification and diminish antioxidant reserves such as glutathione. This biochemical strain could amplify fenbendazole’s hepatotoxic potential. Notably, a study published in Toxicological Sciences found that fenbendazole worsened acetaminophen-induced liver injury in mice by further depleting glutathione and increasing liver enzyme levels.[xiii] More recently, a 2021 case report described acute liver injury in a cancer patient self-administering fenbendazole, with full recovery observed after discontinuing the drug.[xiv] These findings highlight the importance of screening for mycotoxin burden and hepatic function before considering fenbendazole use, as overlapping stressors may compound the risk of adverse liver outcomes.
Liver enzymes AST and ALT are evaluated in a Metabolic Panel Blood test.
🧫 What Are Mycotoxins?
Mycotoxins are secondary metabolites produced by molds, including Aspergillus, Penicillium, Fusarium, and Stachybotrys. These compounds can contaminate indoor environments and food supplies, and they’re known to be carcinogenic, immunosuppressive, and neurotoxic.
- Aflatoxins (from Aspergillus flavus) are classified as Group 1 carcinogens by the IARC and are strongly linked to liver cancer.
- Ochratoxin A and fumonisins have been associated with kidney and esophageal cancers.
- Gliotoxin, a mycotoxin produced primarily by Aspergillus fumigatus, exhibits immunosuppressive, pro-oxidative, and apoptotic effects that may contribute to cancer development by impairing T-cell activation, generating reactive oxygen species (ROS), and inducing DNA damage and mitochondrial dysfunction in host cells.
- Mycotoxins are fat-soluble, meaning they can accumulate in tissues and persist long after exposure.
- The Mosaic Laboratory Urine Test for the Mycotoxins
Aflatoxin M1
Chaetoglobosin A
Citrinin
Dihydrocitrinone
Enniatin B1
Gliotoxin
Mycophenolic Acid
Ochratoxin A
Roridin E
Sterigmatocystin
Verrucarin A
Zearalenone
🌍 How Common Is Mold Exposure?
Mold is ubiquitous. According to the CDC, mold spores are present in most indoor and outdoor environments. However, chronic exposure in water-damaged buildings or contaminated food can lead to toxic buildup.
- Indoor mold is common in homes with leaks, poor ventilation, or high humidity.
- Food contamination is prevalent in grains, peanuts, corn, coffee, and dried fruits.
- A 2022 study found that urine mycotoxin testing revealed significant exposure in patients with chronic fatigue, brain fog, and respiratory symptoms.
🏠 Sources of Mold and Fungus
Mold thrives in damp, poorly ventilated spaces. Common sources include:
- Leaky roofs, windows, or plumbing
- Flooded basements or crawl spaces
- Heating and air conditioning systems and ductwork
- Carpets, drywall, and insulation
- Contaminated food (primarily grains (corn, wheat, rice), nuts, and coffee)
🧪 How to Test Your Home or Workplace
Petri Dish (Settling Plate) Test
This DIY method captures airborne mold spores:
- Initial screening should be done in each room, garage, attic, basement, workshop, and shed. One Petri dish should be placed outside for a control test to see what is normal in your area. Write on each lid the location of the sample.
- Open a petri dish with agar medium and leave it exposed to air for 1 hour.
Do the same with a petri dish outside for 1 hour. - You can use a cotton swab, often provided in a test kit, to test solid surfaces in your home, including walls, counters, sinks, bathtub, carpet, and floors. To test surfaces for mold, use a cotton swab to gently rub across the suspected area in a zigzag motion, avoiding excessive pressure to prevent spreading spores. Immediately, gently rub the swab in a zigzag motion on the Petri dish growth medium.
- Tape the petri dish to the air conditioner and heating vents, and run the system for 10 minutes. This method detects mold circulating through your ventilation system. Placing the petri dish over the air vents, the furthest away from the blower unit, ensures you are covering the whole system.
- Seal the dish and incubate for 48–96 hours.
- Observe mold growth and send it to a lab for identification.
For detailed instructions, see PRO-LAB’s Mold Test Kit Guide.
Amazon also has at-home petri dish mold test kits: https://a.co/d/gBOofmB
Next Steps if You Suspect Mold
Infrared Camera
Using an infrared imaging camera to detect potential mold sources involves scanning for cooler temperature zones that may indicate hidden moisture accumulation. Mold thrives in damp environments, and moisture often causes surfaces to retain less heat, appearing as dark or cool spots on a thermal image. Begin by surveying areas prone to water intrusions, such as around windows, ceilings, plumbing lines, and HVAC systems, especially after rainfall or in humid conditions. Look for irregular temperature patterns rather than straight lines, which may suggest insulation gaps rather than moisture. Once a suspicious cool area is identified, confirm with a moisture meter to verify water presence before remediation. This non-invasive technique allows for early detection and helps prevent costly damage from undetected mold growth.
Amazon Link: https://a.co/d/aXVlD5b
Moisture Meter
Using a moisture meter to evaluate a potential mold source involves scanning surfaces—such as drywall, wood, or flooring—for elevated moisture levels that may support microbial growth. Begin by selecting the appropriate meter type: pin-type meters penetrate the material for precise readings, while pinless meters use electromagnetic sensors for non-invasive scanning. Gently press the meter against the surface and take multiple readings across the area, noting any spots with moisture content above 16–20%, which may indicate a mold-prone zone. For accuracy, compare readings to a known dry baseline and avoid interference from metal fixtures or wiring. If elevated moisture is detected, follow up with visual inspection or infrared imaging to confirm hidden dampness before initiating remediation.
Amazon Link: https://a.co/d/9T6WFZQ
Professional Testing
Professional mold testing is a crucial step in identifying hidden mold growth and evaluating indoor air quality, particularly in homes or workplaces with water damage, musty odors, or unexplained health issues. Certified inspectors use a combination of air sampling, surface swabs, moisture detection, and infrared imaging to pinpoint mold hotspots and determine the type and concentration of spores present. Samples are sent to independent laboratories for analysis, ensuring accurate and unbiased results. Companies offer comprehensive services, including visual inspections, lab reports, and remediation protocols tailored to your environment. This level of testing is especially valuable for individuals with respiratory conditions, compromised immunity, or concerns about mold-related cancer risks.
How to Test Your Body for Mold and Mycotoxins
Urine Mycotoxin Testing
This is the gold standard for detecting mold toxicity in the body:
- Measures excreted mycotoxins like aflatoxins, ochratoxins, and trichothecenes.
- Uses LC-MS/MS technology for high sensitivity.
- Can detect both recent and chronic exposure.
Recommended Laboratory:
To enhance accuracy, take liposomal glutathione for 5–7 days before testing to stimulate detoxification.
🧹 How to Remediate Mold in Your Environment
Effective mold remediation involves:
- Inspection & Assessment – Identify all sources of mold.
- Containment – Isolate affected areas with plastic sheeting.
- HEPA Filtration – Use air scrubbers to remove airborne spores.
- Source Removal – Remove contaminated drywall, insulation, and carpet.
- Cleaning – Scrub surfaces with fungicide and vacuum with HEPA filters.
- Drying – Use dehumidifiers and fans to reduce moisture.
- Post-Remediation Testing – Confirm success with air and surface tests.
For a step-by-step guide, watch SBP’s Mold Remediation Tutorial.
🧘 How to Reduce Mold and Mycotoxins in Your Body
Detox Strategies
- Diet: Avoid sugar and mold-prone foods (corn, peanuts, wheat, grains, nuts and seeds, coffee, chocolate, dried fruits, milk, cheese, butter) until you determine the source of the mycotoxin. Focus on anti-inflammatory, low-glycemic (more paleo to ketogenic) meals. Refrigerating nuts, seeds, coffee, and chocolate may reduce the at-home growth of mold and fungus.
Downloadable Kancer Keto Diet and Palm Rule Guides - Binders: Activated charcoal, bentonite clay, and zeolite help trap mycotoxins in the intestines for removal.
Designs for Health Charcoal Plus Binder (Discount Code: PREVAIL10) - Glutathione: Supports liver detoxification.
This should be used with the guidance of your healthcare team, as it may decrease the effectiveness of some chemotherapy, immunotherapy, and radiation therapy treatments.
Designs for Health Liposomal Glutathione (Discount Code: PREVAIL10) - Infrared Sauna and Exercise: Promotes sweating and toxin release.
Amazon has Blankets from $100, Portable tents from $180, and Wood from $1,500. - Nasal irrigation: Clears mold from the sinuses using saline and antifungal drops.
- Saline Nasal Rinse i.e. NeilMed Sinus Rinse
Amazon Source - NutriBiotic Nasal Spray (Grapefruit Seed Extract)
Amazon Source - Compounding Pharmacies with Rx from healthcare provider
Flourish Compounding Pharmacy
🧬 Final Thoughts
Mold and mycotoxins are silent disruptors of health. Testing your home and body, remediating exposure, and supporting detox pathways can dramatically improve outcomes, especially in cancer prevention and integrative care.
Reference Sources
[i] Claeys L, Romano C, De Ruyck K, et al. Mycotoxin exposure and human cancer risk: A systematic review of epidemiological studies. Comprehensive Reviews in Food Science and Food Safety. 2020;19(4):1449-1464. doi: https://doi.org/10.1111/1541-4337.12567
[ii] Carvajal, M., Berumen, J., & Guardado-Estrada, M. (2012). The presence of aflatoxin B1-FAPY adduct and human papilloma virus in cervical smears from cancer patients in Mexico. Food Additives & Contaminants: Part A, 29(2), 258–268. https://doi.org/10.1080/19440049.2011.647098
[iii] Mafe AN, Büsselberg D. Mycotoxins in Food: Cancer Risks and Strategies for Control. Foods. 2024; 13(21):3502. https://doi.org/10.3390/foods13213502
[iv] https://monographs.iarc.who.int/list-of-classifications
[v] Huybrechts I, Jacobs I, Biessy C, et al. Associations between dietary mycotoxins exposures and risk of hepatocellular carcinoma in a European cohort. PLoS One. 2024;19(12):e0315561. Published 2024 Dec 16. doi:10.1371/journal.pone.0315561 https://pmc.ncbi.nlm.nih.gov/articles/PMC11649147/
[vi] Mafe AN, Büsselberg D. Mycotoxins in Food: Cancer Risks and Strategies for Control. Foods. 2024; 13(21):3502. https://doi.org/10.3390/foods13213502
[vii] Cui A, Hua H, Shao T, et al. Aflatoxin B1 induces Src phosphorylation and stimulates lung cancer cell migration. Tumour Biol. 2015;36(8):6507-6513. doi:10.1007/s13277-015-3341-2 https://pubmed.ncbi.nlm.nih.gov/25820822/
[viii] https://www.walshmedicalmedia.com/open-access/an-overview-on-mycotoxins-causing-cancer-in-human-60542.html
[ix] M.A. Maroui,G.A. Odongo,L. Mundo,F. Manara,F. Mure,F. Fusil,A. Jay,T. Gheit,T.M. Michailidis,D. Ferrara,L. Leoncini,P. Murray,E. Manet,T. Ohlmann,M. De Boevre,S. De Saeger,F. Cosset,S. Lazzi,R. Accardi,[...]& R. Khoueiry, Aflatoxin B1 and Epstein–Barr virus-induced CCL22 expression stimulates B cell infection, Proc. Natl. Acad. Sci. U.S.A. 121 (16) e2314426121, https://doi.org/10.1073/pnas.2314426121 (2024)
[x] Huybrechts I, Jacobs I, Carine Biessy, et al. Associations between dietary mycotoxins exposures and risk of hepatocellular carcinoma in a European cohort. PLoS ONE. 2024;19(12):e0315561-e0315561. doi: https://doi.org/10.1371/journal.pone.0315561
[xi] Kigen, G., Busakhala, N., Kamuren, Z. et al. Factors associated with the high prevalence of oesophageal cancer in Western Kenya: a review. Infect Agents Cancer 12, 59 (2017). https://doi.org/10.1186/s13027-017-0169-y
[xii] Maroui MA, Odongo GA, Mundo L, et al. Aflatoxin B1 and Epstein–Barr virus-induced CCL22 expression stimulates B cell infection. Proceedings of the National Academy of Sciences. 2024;121(16). doi: https://doi.org/10.1073/pnas.2314426121
[xiii] Carol R. Gardner, Vladimir Mishin, Jeffrey D. Laskin, Debra L. Laskin, Exacerbation of Acetaminophen Hepatotoxicity by the Anthelmentic Drug Fenbendazole, Toxicological Sciences, Volume 125, Issue 2, February 2012, Pages 607–612, https://doi.org/10.1093/toxsci/kfr301
[xiv] Teppei Yamaguchi, Junichi Shimizu, Yuko Oya, Yoshitsugu Horio, Toyoaki Hida; Drug-Induced Liver Injury in a Patient with Nonsmall Cell Lung Cancer after the Self-Administration of Fenbendazole Based on Social Media Information. Case Rep Oncol 1 September 2021; 14 (2): 886–891. https://doi.org/10.1159/000516276